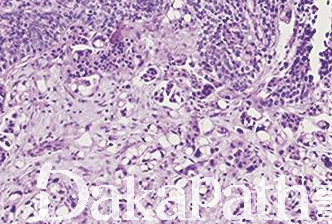
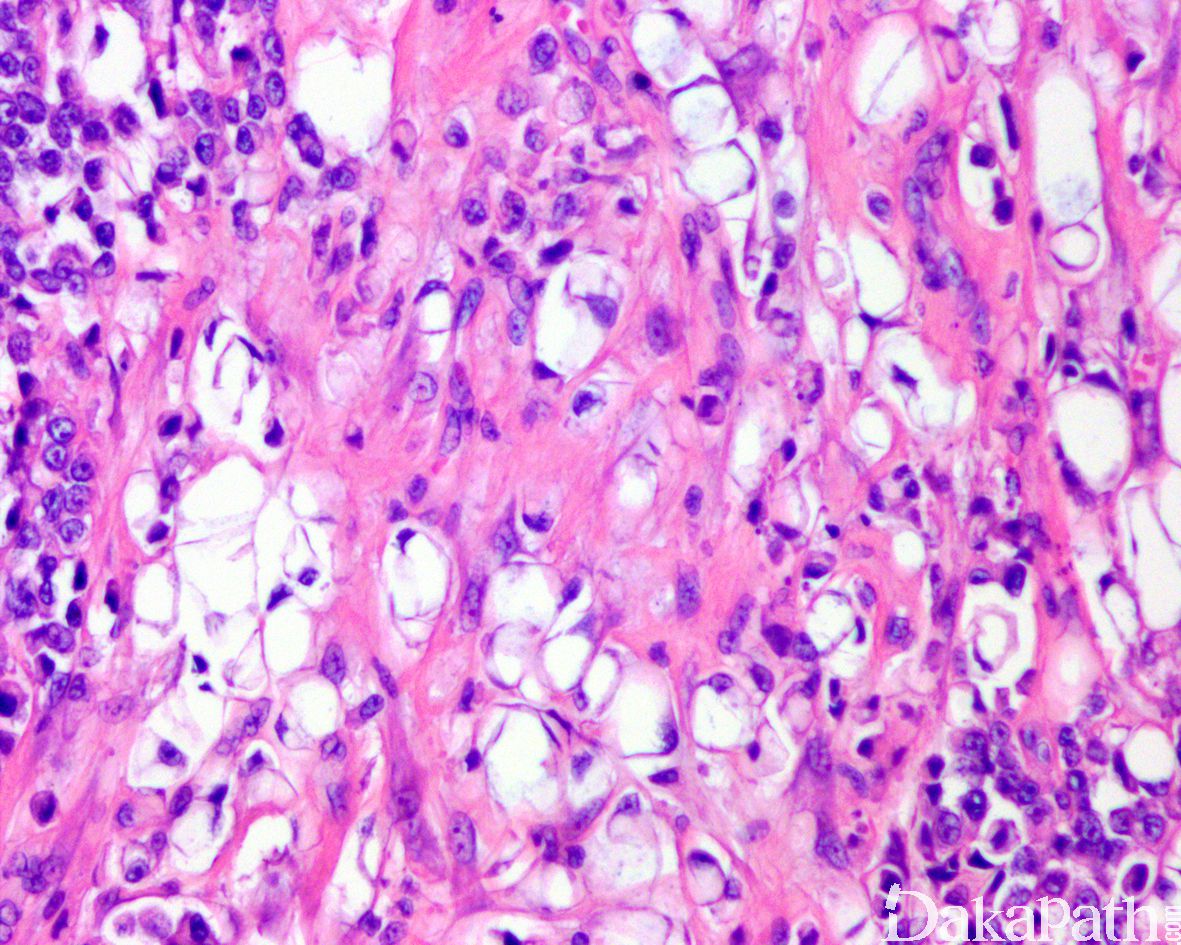

浸润性尿路上皮癌,富脂质
Infiltrating urothelial carcinoma, Lipid-rich
概述:
尿路上皮癌瘤细胞胞浆内存在多个空泡挤压核形成类似于脂肪母细胞的瘤细胞
发病部位: 膀胱、输尿管、肾盂、尿道
诊断要点:
少见,预后差;
特征性形态学改变是存在大的脂肪母细胞样细胞,具有 1 个或多个胞浆空泡,挤压细胞核;
常和其它类型或普通型尿路上皮癌混合存在,脂质细胞通常占肿瘤成分的 10%-50%,
电子显微镜证实胞浆内存在脂质。

免疫组织化学染色:
表达 AE1/3,P63,CK7, thrombomodulin, EMA,Cam5.2,CK20 和 GATA3,Vimentin 和 S100 阴性,黏液染色阴性。
分子标记:
同普通型尿路上皮癌
鉴别诊断:
尿路上皮癌伴异源性 脂肪肉瘤分化 :为真性脂肪母细胞,可表达 S100 蛋白,共表达 CDK4 和 MDM2 等,FISH 检测 MDM2 扩增可资鉴别。
透明细胞尿路上皮癌 :胞浆水样透明,无脂质空泡,无核挤压的切迹,胞浆内物质 PSA 阳性。
印戒细胞癌 :无尿路上皮癌成分,存在胞浆内黏液。
治疗:
经尿道切除或根治性膀胱切除
病例报道:
Case Rep Oncol. --------Lipid Cell and Micropapillary Variants of Urothelial Carcinoma of the Ureter.
Miyama Y1, Morikawa T1, Nakagawa T2, Homma Y2, Fukayama M1. ### Author information
参考文献:
Leroy X, Gonzalez S, Zini L, et al. Lipoid cell variant of urothelial carcinoma: a clinicopathologic and immunohistochemical study of five cases. Am J Surg Pathol 2007;31:770–3. Lopez-Beltran A, Amin MB, Oliveira PS, et al. Urothelial carcinoma of the bladder, lipid cell variant: Clinicopathologic findings and LOH analysis. Am J Surg Pathol. 2010;34:371–6.
